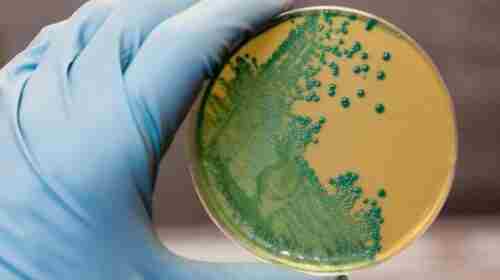

На Дніпропетровщині зафіксовано випадок лістеріозу. Ця інфекція може суттєво нашкодити здоров'ю та призвести навіть до смерті.
У Кривому Розі захворів на лістеріоз у підліток 2013 року народження. Про це повідомляє Криворізький районний відділ Дніпропетровського обласного центру контролю та профілактики хвороб.
Читати даліЗ 2017 року в нашому місті випадки захворювання на лістеріоз не реєструвались.

"КП «Дніпроводоканал» повідомляє, що у зв’язку з необхідністю виконання аварійно-відновлювальних робіт на трубопроводі діаметром 1000 мм, 17:00 30 квітня до 11:00 2 травня буде припинено централізоване водопостачання.
"КП «Дніпроводоканал» повідомляє, що у зв’язку з необхідністю виконання аварійно-відновлювальних робіт на трубопроводі діаметром 1000 мм, 17:00 30 квітня до 11:00 2 травня буде припинено централізоване водопостачання.


